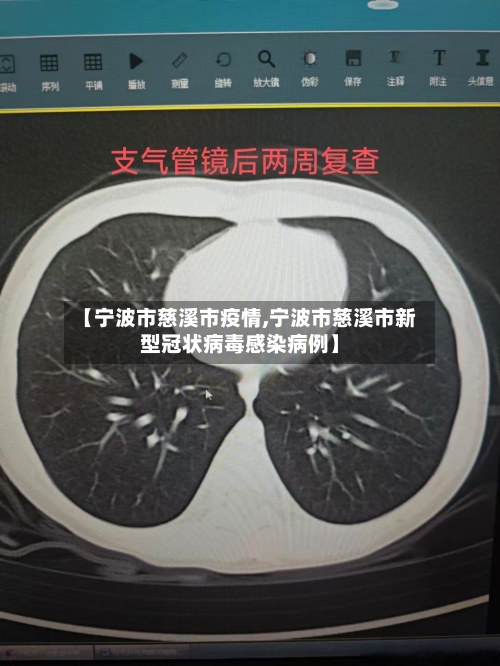
【宁波市慈溪市疫情,宁波市慈溪市新型冠状病毒感染病例】-第1张图片

11月29日宁波慈溪调整临时性管控区域范围
〖壹〗、除观海卫镇临时性管控区域范围和措施维持不变外,市域范围内其他区域恢复常态化疫情防控措施 。龙山镇 、观海卫镇常态化核酸检测频次仍为48小时;龙山镇、观海卫镇有区域核酸检测安排的 ,按照慈溪发布最新通告的区域核酸检测要求执行。
〖贰〗、现将有关要求通告如下:调整周巷镇临时性管控区域:周巷镇天潭村继续保持临时性管控区域范围和措施不变,要求人员“只进不出” 、不集聚、不串门。周巷镇其他临时性管控区域恢复慈溪市的常态化疫情防控措施 。市域范围内其他临时性管控区域的范围和措施维持不变。

〖叁〗、病例15集中隔离点发现,确诊病例11月26日:慈溪市观海卫镇塘下村爱心公寓8幢 、慈溪市福贝贝儿童用品有限公司、古师路韵达快递点;11月27日-28日:观海卫镇塘下村爱心公寓。
〖肆〗、观海卫镇临时性管控区域调整为:东至桃园东路 ,南至三黄线—阳光路—西有江—老塘横河—三黄线,西至三北东路,北至高背浦合围区域;东至新塘横河 ,南至西有江,西至桃园东路,北至高背浦合围区域 。上述区域要求人员“只进不出 ”、不集聚 、不串门。
宁波慈溪封了吗
没有封。据慈溪市防控办和相关部门反馈:近来慈溪加强了疫情防控管理,并没有封城 ,而且物资储备充足,请大家不要惊慌。近来仍处于疫情防控关键阶段,大家千万不能放松警惕 ,请大家不聚集、不扎堆,一定要佩戴好口罩 。请广大市民不造谣、不信谣 、不传谣,涉疫消息以官方发布为准。
没有。慈溪跨海大桥封北起嘉兴市海盐郑家埭 ,止于宁波市慈溪水路湾,全长36公里 。通过查询浙江省宁波市慈溪市道路交通官方网站可知2022年10月4日慈溪跨海大桥并没有因道路问题进行封闭处理。慈溪跨海大桥杭州湾跨海大桥具有重要的意义,它是连接上海、苏南地区与宁波北大门的快速通道。
自相关政策实施起 ,每天全天24小时,在由北环东路、北环西路 、机场北路、机场路、鄞州大道 、鄞县大道、东环南路、东环北路所围成的封闭区域内,禁止摩托车驶入 。宁波中心城区所有高架道路均严禁摩托车通行。
不封。慈溪十一月二十号不封城 ,慈溪,浙江省辖县级市,由宁波市代管,Ⅱ型大城市 。因治南有溪 、东汉董黯“母慈子孝”而得名 ,11月20日,有短视频平台发布:“慈溪封城了,厂里也放假了” ,经核实,此为不实消息。
没有。鸣北小区位于浙江省宁波市慈溪市 。通过查询慈溪市疫情防控中心相关公告了解到,截止2022年11月28日 ,该市的鸣北小区没有出现新冠确诊病例,属于低风险区域,因此并没有进行封闭。但小区用户仍需要定期进行核酸检测结果 ,做好疫情防控相关工作。
有些街道、镇的道路进行封闭式管理模式,外地车辆不能入内。只有329国道线和城区主要通道没有封闭 。

11月21日宁波慈溪市部分区域内学校暂停线下教学
〖壹〗、慈溪市部分区域内学校暂停线下教学根据疫情防控需要,经慈溪市新型冠状病毒感染的肺炎疫情防控工作领导小组研究决定 ,2022年11月21日,慈溪市浒山街道、白沙路街道 、古塘街道、宗汉街道、周巷镇内各级各类学校暂时停止线下教学,各校要有序做好线上教学,确保广大师生停课不停学。各地各校要立即通知学生。后续安排另行通知 。
〖贰〗 、涉及宁波市范围内的公共场所轨迹如下:病例12卡口拦截发现11月20日:杭州湾西高速口、慈溪市浒崇公路珑_府旁加油站、江北区保国寺高速口。
〖叁〗 、月5日 ,浙江省第二区专员公署在宁波成立。10月改称宁波专员公署,慈溪属宁波专员公署 。
〖肆〗、返回宁波市慈溪市【注意】春节农村返乡人员需持7天内有效新冠病毒核酸检测阴性结果,返乡后实行14天居家健康监测 ,期间不聚集、不流动,每7天开展一次核酸检测。(返乡人员指从外地返回农村地区的人员,持核酸检测阴性证明返乡时间为1月28日—3月8日 ,返乡不满14天以实际返乡时间居家监测。
〖伍〗 、宁波卫健委通报2022年11月20日6-21时,宁波市新增1例新冠肺炎确诊病例、8例新冠肺炎无症状感染者 。近来上述病例已闭环转运至定点医院,已排查到的密接人员均已落实相应管控措施。涉及宁波市范围内的公共场所轨迹如下:病例2卡口拦截发现11月19日:镇海区九龙湖高速口。
〖陆〗、截至2022年11月24日24时 ,全市累计报告确诊病例523例 。涉及宁波市范围内的公共场所轨迹如下:病例1集中隔离点发现,无症状感染者11月20日:海曙区洞桥镇鱼山头村方兴食品有限公司 、鱼山头村胖子超市、鱼山头村皖北小吃。
长河疫情怎么样
〖壹〗、不严重。通过查询浙江慈溪2022年9月13日最新疫情动态,该地区近来无一人感染 ,处于无风险地区,所以不严重。慈溪是浙江省的园林城市、文明城市 、福布斯中国前十最富有县级市之一 。
〖贰〗、风险等级详情中风险地区:杭州市滨江区长河街道建业路151号(慧而特(中国)餐饮设备有限公司)。低风险地区:上城区、下城区 、江干区、拱墅区、西湖区 、萧山区、余杭区、富阳区 、临安区等区域均为低风险地区。
〖叁〗、滨江区长河街道建业路151号[慧而特(中国)餐饮设备有限公司]其余4个中风险地区位于富阳区,分别为:富阳区润泽院富阳区富春街道桂花西路262号富阳区洞桥镇贤德村何村坞168号富阳区咕甜全球母婴店除上述中高风险地区外,杭州其余地区均为低风险地区 。
11月27日宁波慈溪市临时性管控范围调整
〖壹〗、关于调整慈溪市临时性管控区域范围的通告鉴于当前严峻复杂的疫情形势 ,经市疫情防控领导小组研究决定,自即日起,对慈溪市临时性管控区域范围进行调整。
〖贰〗 、关于调整部分临时性管控区域范围的通告鉴于当前疫情形势 ,经市疫情防控工作领导小组研究决定,自即日起,对慈溪市部分临时性管控区域范围进行调整。现将有关要求通告如下:调整周巷镇临时性管控区域:周巷镇天潭村继续保持临时性管控区域范围和措施不变 ,要求人员“只进不出 ”、不集聚、不串门 。
〖叁〗、宁波临时性管控区域汇总鄞州区自11月24日4时起,对鄞州区部分区域范围执行疫情防控临时性管控措施。对宁波诺丁汉大学 、鄞州区人才公寓实施临时管控,人员“只进不出”、不集聚、不串门。高新区交通紫园小区 、丁香苑南区和梅江北苑等3个小区继续执行临时性管控措施 。
〖肆〗、宁波疫情通报2022年11月27日17-24时 ,新增3例新冠肺炎确诊病例、19例新冠肺炎无症状感染者。近来上述病例已闭环转运至定点医院,已排查到的密接人员均已落实相应管控措施。涉及宁波市范围内的公共场所轨迹如下:病例25卡口拦截发现,无症状感染者11月26日:江北慈城高速口 。
宁波哪里有疫情最新情况
〖壹〗 、021年12月6日16时起 ,浙江省宁波市镇海区蛟川街道的临江小区和宁波阿尔卑斯电子有限公司被列为中风险地区,其他地区均为低风险地区。具体说明如下:中风险地区范围 临江小区:位于宁波市镇海区蛟川街道,因疫情防控需要被划定为中风险区域。宁波阿尔卑斯电子有限公司:同样位于镇海区蛟川街道,与临江小区同步列为中风险地区。
〖贰〗、宁波浙江万里学院疫情最新情况:2022年4月12日中午 ,鄞州区报告1例新冠病毒初筛阳性感染者,为浙江万里学院钱湖校区大四学生 。该生已完成新冠疫苗3针接种,采样已送宁波市疾控中心复核。鄞州区已启动应急响应机制 ,开展流调溯源、隔离管控 、核酸检测等工作,并对居住场所进行环境采样检测及消毒。
〖叁〗、月1日以来,宁波市北仑区累计报告新冠肺炎确诊病例23例 ,且病例高度集中在北仑区申洲公司制衣三部车间 。针对此次疫情,宁波市相关部门已迅速展开流调和排查工作,累计排查密接人员3387人 ,次密接人员980人,参照密接人员管理8526人,并均已按要求落实了管控措施。
〖肆〗、宁波海曙区发布最新疫情防控通告 ,浙江杭州 、丽水、金华多地紧急寻人,相关人员请立即上报并配合防控措施。
〖伍〗、截至4月8日24时,新型冠状病毒肺炎疫情最新情况如下:新增确诊病例:全国31个省(自治区、直辖市)和新疆生产建设兵团报告新增确诊病例1350例 。
本文来自作者[rztrade]投稿,不代表温岭网立场,如若转载,请注明出处:https://m.rztrade.cn/wenling/36471.html
评论列表(4条)
我是温岭网的签约作者“rztrade”!
希望本篇文章《【宁波市慈溪市疫情,宁波市慈溪市新型冠状病毒感染病例】》能对你有所帮助!
本站[温岭网]内容主要涵盖:温岭网,生活百科,小常识,生活小窍门,百科大全,经验网,游戏攻略,新游上市,游戏信息,端游技巧,角色特征,游戏资讯,游戏测试,页游H5,手游攻略,游戏测试,大学志愿,娱乐资讯,新闻八卦,科技生活,校园墙报
本文概览:11月29日宁波慈溪调整临时性管控区域范围〖壹〗、除观海卫镇临时性管控区域范围和措施维持不变外,市域范围内其他区域...